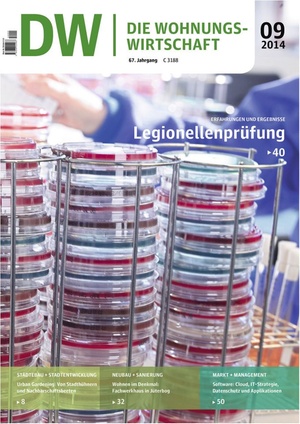
Die Wohnungswirtschaft 09/2014 | Wohnungswirtschaft

Unser Ziel ist es, Ihnen eine auf Ihre Bedürfnisse zugeschnittene Website anzubieten. Um Ihnen relevante und nützliche Inhalte, Angebote und Services präsentieren zu können, benötigen wir Ihre Einwilligung zur Nutzung Ihrer Daten. Wir nutzen den Service eines Drittanbieters, um Ihre Aktivitäten auf unserer Website zu analysieren.
Mit Ihrer Einwilligung profitieren Sie von einem personalisierten Website-Erlebnis und Zugang zu spannenden Inhalten, die Sie informieren, inspirieren und bei Ihrer täglichen Arbeit unterstützen.
Wir respektieren Ihre Privatsphäre und schützen Ihre Daten. Sie können sich jederzeit darüber informieren, welche Daten wir erheben und wie wir sie verwenden. Sie können Ihre Einwilligung jederzeit widerrufen. Passen Sie Ihre Präferenzen dafür in den Cookie-Einstellungen an.